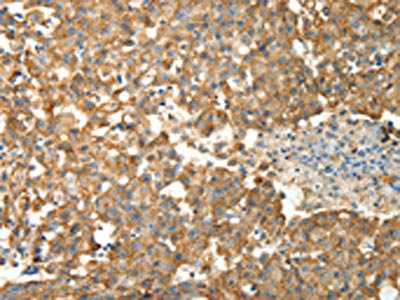

PRDX3 Antibody
-
中文名稱(chēng):PRDX3兔多克隆抗體
-
貨號(hào):CSB-PA195573
-
規(guī)格:¥1100
-
圖片:
-
The image on the left is immunohistochemistry of paraffin-embedded Human breast cancer tissue using CSB-PA195573(PRDX3 Antibody) at dilution 1/50, on the right is treated with fusion protein. (Original magnification: ×200)
-
The image on the left is immunohistochemistry of paraffin-embedded Human thyroid cancer tissue using CSB-PA195573(PRDX3 Antibody) at dilution 1/50, on the right is treated with fusion protein. (Original magnification: ×200)
-
Gel: 10%SDS-PAGE, Lysate: 40 μg, Lane 1-5: Hela cells, 293T cells, MCF7 cells, human fetal brain tissue, Jurkat cells, Primary antibody: CSB-PA195573(PRDX3 Antibody) at dilution 1/800, Secondary antibody: Goat anti rabbit IgG at 1/8000 dilution, Exposure time: 2 seconds
-
-
其他:
產(chǎn)品詳情
-
Uniprot No.:
-
基因名:
-
別名:Antioxidant protein 1 antibody; AOP 1 antibody; AOP-1 antibody; AOP1 antibody; HBC189 antibody; MER5 antibody; MGC104387 antibody; MGC24293 antibody; mitochondrial antibody; peroxiredoxin 3 antibody; Peroxiredoxin III antibody; Peroxiredoxin-3 antibody; PRDX3 antibody; PRDX3_HUMAN antibody; PRO1748 antibody; Protein MER5 homolog antibody; PRX III antibody; Prx-III antibody; PRX3 antibody; SP 22 antibody; SP-22 antibody; SP22 antibody; Thioredoxin dependent peroxide reductase mitochondrial antibody; Thioredoxin-dependent peroxide reductase antibody
-
宿主:Rabbit
-
反應(yīng)種屬:Human,Mouse,Rat
-
免疫原:Fusion protein of Human PRDX3
-
免疫原種屬:Homo sapiens (Human)
-
標(biāo)記方式:Non-conjugated
-
抗體亞型:IgG
-
純化方式:Antigen affinity purification
-
濃度:It differs from different batches. Please contact us to confirm it.
-
保存緩沖液:-20°C, pH7.4 PBS, 0.05% NaN3, 40% Glycerol
-
產(chǎn)品提供形式:Liquid
-
應(yīng)用范圍:ELISA,WB,IHC
-
推薦稀釋比:
Application Recommended Dilution ELISA 1:2000-1:5000 WB 1:500-1:2000 IHC 1:50-1:200 -
Protocols:
-
儲(chǔ)存條件:Upon receipt, store at -20°C or -80°C. Avoid repeated freeze.
-
貨期:Basically, we can dispatch the products out in 1-3 working days after receiving your orders. Delivery time maybe differs from different purchasing way or location, please kindly consult your local distributors for specific delivery time.
-
用途:For Research Use Only. Not for use in diagnostic or therapeutic procedures.
相關(guān)產(chǎn)品
靶點(diǎn)詳情
-
功能:Thiol-specific peroxidase that catalyzes the reduction of hydrogen peroxide and organic hydroperoxides to water and alcohols, respectively. Plays a role in cell protection against oxidative stress by detoxifying peroxides. Acts synergistically with MAP3K13 to regulate the activation of NF-kappa-B in the cytosol.
-
基因功能參考文獻(xiàn):
- tubular PRX3 in combination with conventional predictors can further improve recovery prediction and may help with risk stratification in AKI patients with pre-existing CKD. PMID: 28240739
- results suggest that decreased PRDX3 by excessive bile acids in trophoblasts plays a critical role in the pathogenesis and progression of Intrahepatic cholestasis of pregnancy. PMID: 27958341
- Mutants created to investigate link between oligomerisation and peroxidase activity. Obligate dimer is less active than wildtype but still displays peroxidase activity. 2.4A structure (PDB: 5UCX) shows cysteine-stabilised protein interface. PMID: 29438714
- the present study identified the protein profiles of the PRDX family in LSCC and showed that down-regulation of PRDX3 in Hep-2 cells induced cell apoptosis and inhibited cell proliferation and cell migration. PMID: 27966448
- The UNG1-PRDX3 interaction protected UNG1 from reactive oxygen species-mediated degradation and prevented mitochondrial DNA oxidation. PMID: 27480846
- PRDX3 knockdown led to the down-regulation of ATP synthases and the decreased cellular ATP level, contributing to the slow-down of cell growth. Furthermore, silencing PRDX3 enhanced invasive properties of HepG2 cells via TIMP-1 down-regulation and the increased ECM degradation PMID: 26983019
- Prx3 and Trx2 comprise an adaptive system to sense changes in atmospheric oxygen tension and influence cellular injury responses through both detoxification of mitochondrial oxidants and regulation of mitochondrial redox-dependent signaling PMID: 28045936
- PRX3 plays a crucial role in mitochondrial homeostasis. PMID: 27037278
- High PRX3 expression is associated with invasion of lung adenocarcinoma. PMID: 26810067
- We also found that forkhead box protein 1 (FOXM1)-induced peroxiredoxin 3 (PRDX3) maintains the mitochondrial function, and the FOXM1/PRDX3 mitochondrial pathway maintains survival of colon CSCs PMID: 26350748
- Oxidative stress promotes PRX2 and PRX3 hyperoxidation and attenuates pro-survival signaling in aging chondrocytes. PMID: 26797130
- the species with one disulfide and one hyperoxidized active site was decameric for Prx2 and dimeric for Prx3. Reduction and re-oxidation of the hyperoxidized dimer of Prx3 produced hyperoxidized monomers PMID: 26614766
- Data indicate that peroxiredoxin III (PrxIII) is a common direct target of both miroRNAs miR-26a-5p and miR-23b-3p. PMID: 24828865
- Colon cancer stem cells overexpress the mitochondrial gene PRX3, which is required for maintenance of mitochondrial function and tumorigenesis, and is regulated by forkhead box protein 1, which also regulates expression of CD133 in these cells. PMID: 26091938
- High serum PRDX3 levels are associated with hepatocellular carcinoma. PMID: 25743848
- Peroxiredoxin 3 levels regulate a mitochondrial redox setpoint in malignant mesothelioma cells. PMID: 25462069
- two placental proteins, Prx3 and Prx4, may act as new placental immune targets. PMID: 25323516
- Serum PRDX3 can be used as a noninvasive biomarker for the diagnosis and/or prognosis of hepatocellular carcinoma. PMID: 24815434
- High peroxiredoxin 3 protein expression is associated with hepatocellular carcinoma. PMID: 24105047
- HIF-1alpha is a transcription factor for PRDX3 gene expression in clear cell renal cell carcinoma. PMID: 25093297
- Data indicate that engineered Prx2 and Prx3 variants C-terminal residues modulate the extent of hyperoxidation. PMID: 24003226
- The silencing of PRDX3 triggered cisplatinmediated apoptosis in the ovarian cancer cells, which may act through suppression of the NFkappaB signaling pathway. PMID: 23503975
- Results suggest that PRDX-3 has an essential role in regulating oxidation-induced apoptosis in antiandrogen-resistant prostate cancer cells. PMID: 23880827
- peroxiredoxin III may be associated with drug resistance in ovarian cancer PMID: 23564483
- A fraction of FOXM1 coexists in the cytoplasm with mitochondrial peroxiredoxin 3. PMID: 23018647
- Drug resistance formation was accompanied by a significant increase in the expression of PRDX1, PRDX2, PRDX3, PRDX6 genes in all cancer cell strains, which confirms the importance of redox-dependent mechanisms into development of cisplatin resistance. PMID: 23113308
- Medulloblastoma tumors exhibit decreased expression of miR-383 but elevated expression of PRDX3. Up-regulation of miR-383 knocks down the expression of PRDX3, inhibits cell proliferation and promotes apoptosis. PMID: 23157748
- the effects of PRDX3 in PCa progression may be caused by the regulation function of miR-23b, and consequently, miR-23b may be involved in the response of PCa cells to hypoxia stress PMID: 22710126
- Single nucleotide polymorphisms in the PRDX3 and RPS19 is associated with HPV persistence and cervical precancer/cancer. PMID: 22496757
- The results indicated that overexpression of PRDX3 was associated with 94.9% hepatocellular carcinoma, and correlated with poor differentiation (P<0.05), which suggest that PRDX3 has substantial clinical impact on the progression of hepatocarcinoma. PMID: 22344546
- Report nuclear factor E2-related factor 2 dependent overexpression of sulfiredoxin and peroxiredoxin III in human lung cancer. PMID: 22016591
- Cullin 4B protein ubiquitin ligase targets peroxiredoxin III for degradation. PMID: 21795677
- The interaction between genetic variations in the PRDX3 gene and dietary fat intake is important for modulation of BMI and obesity risk. PMID: 21127481
- Model for the exceptional reactivity of peroxiredoxins 2 and 3 with hydrogen peroxide: a kinetic and computational study. PMID: 21385867
- Paraneoplastic autoimmune reaction against retinal pigment epithelium, with PRDX3 as the putative antigen, may be a cause of acute exudative polymorphous vitelliform maculopathy (AEPVM). PMID: 21220625
- Both thioredoxin 2 and glutaredoxin 2 contribute to the reduction of the mitochondrial 2-Cys peroxiredoxin Prx3. PMID: 20929858
- Prx3, which resides within mitochondria, were reacted with a selection of hydroperoxides generated by gamma-radiolysis or singlet oxygen, on free amino acids, peptides and proteins. PMID: 20840079
- Peroxiredoxin III was significantly up-regulated in cervical cancer tissues. PMID: 20718351
- Peroxiredoxin III has a significant role in cell cycle regulation and could be a potential proliferation marker in breast cancer. PMID: 20043069
- Protein levels of Prx-III, a mitochondrial protein were significantly decreased in Alzheimer Disease and Down Syndrome. PMID: 11771746
- Proteomics analysis of cellular response to oxidative stress. Evidence for in vivo overoxidation of peroxiredoxins at their active site PMID: 11904290
- PRDX3 is a c-Myc target gene that is requried to maintain normal mitochondrial function. c-Myc directly activates expression of a mitochondrial peroxiredoxin that is required for Myc-mediated transformation. PMID: 12011429
- LZK was associated directly with the IKK complex through the kinase domain, and that AOP-1 was recruited to the IKK complex through the binding to LZK. PMID: 12492477
- The level of peroxiredoxin 3 is decreased in the frontal cortex of patients with Down syndrome and Pick's disease. PMID: 12650976
- Peroxiredoxin III is a critical regulator of the abundance of mitochondrial H(2)O(2), which itself promotes apoptosis in cooperation with other mediators of apoptotic signaling PMID: 15280382
- findings indicate that RPK118 is a PRDX3-binding protein that may be involved in transporting PRDX3 from the cytoplasm to its mitochondrial site of function or to other membrane structures via endosome trafficking. PMID: 15750338
- The additive protection by Trx2 and GSH shows that Trx2 and GSH systems are both functionally important at low oxidative stress conditions. PMID: 17548047
- Finally, the expression level of beta-globin and GATA-1 was dramatically increased in Prdx III O/E cell line. PMID: 17574212
- Present throughout lens and localized to mitochondria in lens epithelial cells. Induction is acute response of lens to increased H2O2. Important role in lens H2O2-detoxification, mitochondrial maintenance, and possibly cataract formation. PMID: 17893648
- FOXO3A mediates Prx III expression, and this may play a critical role in the resistance to oxidative stress in cardiac fibroblasts PMID: 18195003
顯示更多
收起更多
-
亞細(xì)胞定位:Mitochondrion. Cytoplasm. Early endosome.
-
蛋白家族:Peroxiredoxin family, AhpC/Prx1 subfamily
-
數(shù)據(jù)庫(kù)鏈接:
Most popular with customers
-
-
YWHAB Recombinant Monoclonal Antibody
Applications: ELISA, WB, IHC, IF, FC
Species Reactivity: Human, Mouse, Rat
-
Phospho-YAP1 (S127) Recombinant Monoclonal Antibody
Applications: ELISA, WB, IHC
Species Reactivity: Human
-
-
-
-
-